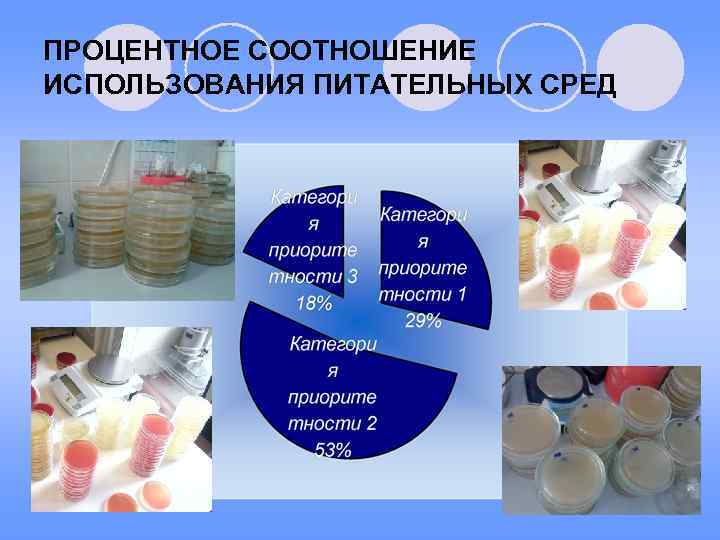
ПРОЦЕНТНОЕ СООТНОШЕНИЕ ИСПОЛЬЗОВАНИЯ ПИТАТЕЛЬНЫХ СРЕД

ГОСУДАРСТВЕННОЕ АВТОНОМНОЕ.ppt
- Количество слайдов: 12

ГАОУ СПО «Казанский медицинский колледж» ОБОСНОВАНИЕ ВЫБОРА ПИТАТЕЛЬНЫХ СРЕД И ДИАГНОСТИЧЕСКИХ РЕАГЕНТОВ ДЛЯ ПРОВЕДЕНИЯ МИКРОБИОЛОГИЧЕСКИХ ИССЛЕДОВАНИЙ Работу выполнила студентка КМК: Газизова Миляуша Мунировна группа 7301 Руководитель: Круглова Зульфия Фенуновна

АКТУАЛЬНОСТЬ ВЫБРАННОЙ ТЕМЫ

ВЫДЕЛЯЮТ СЛЕДУЮЩИЕ КАТЕГОРИИ ПРИОРИТЕТНОСТИ ДЛЯ ПИТАТЕЛЬНЫХ СРЕД И РЕАГЕНТОВ l Категории 1. Каждая лаборатория, где производят общие диагностические бактериологические исследования, должна быть укомплектована питательными средами и реагентами, отнесенными к высокому уровню приоритетности. В большинстве своем это среды и реагенты многоцелевого назначения, несложные для приготовления; обычно их немного. l Категория 2. Питательные среды и реагенты, отнесенные к среднему уровню приоритетности, - это дополнительные полезные материалы, позволяющие проводить более сложные и всесторонние лабораторные диагностические исследования, способствуя совершенствованию эпидемиологических исследований, хотя и не всегда необходимые для оказания немедленной помощи пациенту. l Категория 3. Питательные среды и реагенты, отнесенные к низкому уровню приоритетности, - это вещества, редко используемые для диагностических тестов в отношении конкретных пациентов, однако они весьма полезны в учебных, исследовательских и специализированных справочных лабораториях. Эта категория объединяет среды и реагенты, которые либо слишком дороги для использования в повседневной работе, либо требуются для выявления редко встречающихся или с трудом выявляемых микроорганизмов, в отношении которых показатель «затраты – эффективность» будет, вероятно, низок.

ЦЕЛЬ ИССЛЕДОВАНИЯ l Изучить установления приоритетов для питательных сред, микротест - систем и диагностических реагентов в микробиологической лаборатории ГАУЗ «РКОД МЗ РТ» . l Объекты исследования: биологический инфекционный материал (кровь, выпотные жидкости, моча, кал, мокрота, мазок из зева, отделяемое ран), которые высеивались на питательные среды средами с различными категориями приоритетности.

ЗАДАЧИ ИССЛЕДОВАНИЯ l 1) Изучить питательные среды и определить категорию приоритетности для выделения и идентификации патогенов из биологического материала (кровь, выпотные жидкости, моча, кал, мокрота, мазка из зева, отделяемое ран). l 2) Изучить использование микротест- систем и определить категорию приоритетности.

БИОЛОГИЧЕСКИЙ МАТЕРИАЛ

БИОЛОГИЧЕСКИЙ МАТЕРИАЛ И РЕГИСТРАЦИЯ
ПРОЦЕНТНОЕ СООТНОШЕНИЕ ИСПОЛЬЗОВАНИЯ ПИТАТЕЛЬНЫХ СРЕД

ПРОЦЕНТНОЕ СООТНОШЕНИЕ ИСПОЛЬЗОВАНИЯ МИКРОТЕСТ- СИСТЕМ

ПРОЦЕНТНОЕ СООТНОШЕНИЕ ИСПОЛЬЗОВАНИЯ ПИТАТЕЛЬНЫХ СРЕД ДЛЯ РАЗЛИЧНОГО БИОЛОГИЧЕСКОГО МАТЕРИАЛА 1. Кровь 2. Выпотные жидкости 3. Мочевыделит ельная система 4. ЖКТ 5. Нижние и верхние дыхательн ые пути 6. Мазок из зева

РЕКОМЕНДАЦИИ l В результате проведенного исследования в микробиологической лаборатории ГАУЗ «РКОД МЗ РТ» рекомендуется использовать питательные среды и реагенты относящиеся ко 2 -ой категории приоритетности. l Рекомендуем использовать микротест-системы производящие в нашей стране. Такие тест-системы производят в Ставрополе (ФГУП "Аллерген"), Махачкале (НПО "Питательные среды"), Нижнем Новгороде (НПО "Диагностические системы"), Санкт. Петербурге (НИИЭМ им. Л. Пастера) с целью экономии финансовых затрат.

СПАСИБО ЗА ВНИМАНИЕ!
ГОСУДАРСТВЕННОЕ АВТОНОМНОЕ.ppt